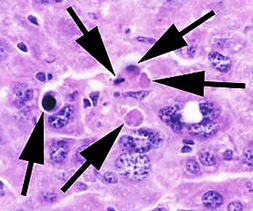
<p><strong>Councilman bodies</strong> (apoptotic acidophilic inclusions) in the liver.</p>

1/72
Looks like no tags are added yet.
Name | Mastery | Learn | Test | Matching | Spaced |
|---|
No study sessions yet.
What is the genome structure of Human Immunodeficiency Virus 1?
Retroviridae, with 2 copies of positive-sense ssRNA and is enveloped.
What is the viral attachment protein of HIV-1?
gp160, which is made of gp120 and gp41.

What is the primary receptor for HIV-1?
CD4.

What are the coreceptors for HIV-1?
CCR5 (on T cells, macrophages, dendritic cells) and CXCR4 (on T cells).

What are the target cells of HIV-1?
CD4 T cells (T-tropic) and macrophages/dendritic cells (M-tropic).
How is HIV-1 transmitted?
Through sexual contact, blood, semen, vaginal secretions, maternal-fetal transmission, and breast milk.
What are the three major genes of HIV-1 and what do they encode?
Gag – encodes nucleocapsid core and capsid proteins (p24, p17, p9, p7)
Pol – encodes replication enzymes (reverse transcriptase, integrase, protease)
Env – encodes envelope glycoproteins (gp120, gp41)

Describe the process of HIV-1 replication and the steps targeted by antiviral drugs.
gp120 binds to CD4 and CCR5 or CXCR4 on the host cell. (Entry inhibitors target this step)
gp120/gp41 changes shape and exposes the fusion peptide, allowing the virus to fuse with the host cell membrane. (Fusion inhibitors target this step)
Capsid is released into the cytoplasm and uncoated.
Viral RNA is reverse transcribed into double-stranded DNA by reverse transcriptase (RT). The viral RNA is degraded. (Reverse transcriptase inhibitors target this step)
Viral DNA enters the nucleus and is integrated into the host genome by integrase. (Integrase inhibitors target this step)
Host cell transcribes proviral DNA into genomic RNA and mRNA for protein production. Both forms move to the cytoplasm.
Viral proteins are synthesized and processed by viral protease. (Protease inhibitors target this step)
New viral particles assemble at the cell membrane and bud off. Protease cleaves polyproteins, producing mature infectious virions. (Protease inhibitors also target this step)

What are the drug targets in the HIV-1 replication process?
Entry inhibitors block step 1 (gp120 binding) and step 2 (fusion).
Reverse transcriptase inhibitors block step 4 (conversion of RNA to DNA).
Integrase inhibitors block step 5 (integration of viral DNA into host genome).
Protease inhibitors block step 7 (protein processing) and step 8 (maturation of new virions).
Why does HIV have a high mutation rate?
Because its reverse transcriptase is error-prone and lacks proofreading, leading to frequent mutations.
How does HIV infection affect T cells?
HIV causes both lytic and latent infections in T cells, reducing CD4 numbers through direct viral lysis and immune-mediated killing.

How does HIV impact immunity?
Loss of CD4 cells reduces Th cell activity, IL-2, and IFN-γ production, leading to decreased CD8 and macrophage function.
It also alters cytokine production and increases non-specific antibody production (hypergammaglobulinemia).

What makes HIV-1 hard to clear from the body?
Destruction of the immune system – allows for opportunistic infections
Viral replication in immunoprivileged sites
Viral latency
Antigenic variation
Direct cell-to-cell transmission of virus

How does HIV-1 disease progress?
Acute phase: CD4 count >500 cells/µl, flu-like symptoms.
Latent phase: CD4 count 200-500 cells/µl, asymptomatic, viral shift to T-tropic X4 viruses.
Full-blown AIDS: CD4 count <200 cells/µl, with opportunistic infections or cancer.

How can HIV-1 be prevented?
Through behavioral changes,
Using Nonoxynol-9,
Post-exposure Anti Retroviral Therapy.


How is HIV tested according to the CDC/APH guidelines?
Initial EIA: Detects p24 antigen and HIV-1/2 IgM/IgG antibodies.
Confirmatory EIA: If positive, distinguishes HIV-1 vs. HIV-2 antibodies.
Nucleic Acid Test: Done if results are indeterminate to confirm HIV-1 infection.
What viruses are included in the Flaviviridae family?
Dengue virus, Yellow fever virus, West Nile virus, Zika virus, Japanese encephalitis virus, and tick-borne encephalitis virus.

How is Flaviviridae transmitted?
Mainly by mosquito or tick vectors (arboviruses).
Human-to-human transmission can happen through blood/platelet transfusion (all), sexual and vertical (Zika).

Which mosquitos transmit yellow fever, Dengue, and Zika viruses?
Aedes mosquitos

Which mosquitos transmit West Nile and Japanese Encephalitis Virus
Culex mosquitos
Where are Aedesmosquitos found in the US?
Aedes aegypti and Ae. albopictus are found mostly in the southern and eastern US.

How are most flavivirus cases (except West Nile) in the US acquired?
Most cases are from people who recently traveled internationally or immigrated.

What cells do the Flaviviridae viruses target?
Monocytes, macrophages, dendritic cells, leading to viremia and spreading to the brain, liver, vasculature, and skin.
How is Flaviviridae prevented?
Behavior changes (clothing, repellents), mosquito control, and live-attenuated vaccines for Yellow Fever and JEEV.
What is the key pathophysiological response in Dengue virus infection?
Increased vascular permeability, causing plasma leakage, microvascular bleeding, and reduced coagulation.
What are the 4 distinct strains of dengue virus
DENV-1, DENV-2, DENV-3, and DENV-4.
Each strain is antigenically different, meaning infection with one strain provides lifelong immunity to that strain but not to the others. Reinfection with a different strain increases the risk of severe disease like Dengue Hemorrhagic Fever or Dengue Shock Syndrome
What are symptoms of the primary infection/acute dengue or "break-bone fever"?
Severe headache, retro-orbital pain, fever, rash, bruising, joint pain, vomiting, and mild hemorrhagic events like nosebleeds and petechiae.

What is Dengue Hemorrhagic Fever and when does it occur?
Severe disease that usually occurs during re-infection with a different strain; can involve bleeding in multiple organs and fluid pooling.


What is Antibody-Dependent Enhancement?
A process where antibodies bind to a virus but don’t block it. Instead, they help the virus enter immune cells (like macrophages) through Fc receptors, leading to more infection and worse disease. This can happen during a second infection with a different strain, like in dengue.


What are the three possible disease outcomes of West Nile Virus infection?
Asymptomatic: ~80% have no symptoms.
Acute (West Nile fever): ~20% develop fever, headache, tiredness, body aches, occasional rash.
Severe (encephalitis or meningitis): ~1% develop severe illness, especially in the elderly.

What are the two stages of Yellow Fever Virus disease?
Acute stage: Flu-like symptoms; most clear infection here.
Severe stage (Yellow stage): 1 in 17 progress; symptoms include high fever, black vomit (GI hemorrhage), jaundice, renal failure, coma, and death possible.

Hallmark symptom of severe yellow fever?
Black vomit due to GI hemorrhage

What is a hallmark/unique pathological finding in Yellow Fever?
Councilman bodies (apoptotic acidophilic inclusions) in the liver.
How is Yellow Fever Virus prevented?
Live-attenuated vaccine developed by Major Walter Reed in the late 1890s; available for travelers to endemic areas.

How is Zika Virus transmitted?
Mosquito, in utero, sexual (semen, vaginal fluid), saliva, blood/platelet donation, and possibly breast milk.

What are the symptoms of symptomatic Zika infection?
Conjunctivitis, headache, retro-orbital pain, fever, malaise, arthralgia, and rash.

What type of virus is Chikungunya Virus?
Positive-sense ssRNA, enveloped, and has an icosahedral capsid.

How is Chikungunya Virus transmitted?
Through a vector, specifically the Aedes mosquito.

What cells does ChikV target?
A broad variety of cells
What was the original vector for Chikungunya Virus?
Aedes aegypti.
What mutation allowed Chikungunya virus to expand to a new vector species?
A single point mutation in the E1 glycoprotein allowed the virus to expand to Aedes albopictus, which is more aggressive, feeds all day, and tolerates cooler temperatures, increasing the virus's potential for spread.

What are the acute symptoms of Chikungunya virus?
High fever, headache, back pain, myalgia, arthralgia, and possible rash. Arthralgia can be severe, mainly in the extremities and large joints.

What happens during the recurrent phase of Chikungunya?
Crippling arthralgia in small joints of hands, wrists, ankles, and feet, lasting 7-10 days per episode with recurrent episodes for months to years.

What is the cause of recurrent disease in Chikungunya?
It is immune-mediated and may be due to persistent infection of macrophages traveling to joint spaces.


How can you differentiate between Zika, Dengue and Chikugunya?
Differentiation based on symptoms:
Zika Virus: Rash is very prominent (+++)
Dengue Virus: Myalgia is significant (++)
Chikungunya: Arthralgia (Severe joint pain) = hallmark symptom


How are most bunyaviruses transmitted, and what is the exception?
Most bunyaviruses are arboviruses, transmitted by arthropod bites (mosquitoes, ticks) or contact with infected livestock.
Exception: Hantaviruses which are zoonotic


What are hantaviruses?
Viruses carried by rodents (like mice and rats). People can get infected by breathing in dust contaminated with rodent urine, droppings, or saliva.
Hantaviruses can cause serious diseases like Hantavirus Pulmonary Syndrome or Hemorrhagic Fever with Renal Syndrome

How is Hantavirus Pulmonary Syndrome transmitted?
By contact with rodents and their excretions (urine, feces) through inhalation.

How does Hantavirus hemorrhagic fever lead to kidney failure?
Hantavirus hemorrhagic fever targets vascular endothelial cells, causing blood vessel damage.
This leads to leaking blood vessels and reduced blood flow to the kidneys, which can make the kidneys fail.


What affects the geographic distribution of Arenaviridae diseases?
The location of the rodent reservoir, which varies with each virus.

Why are Arenaviridae diseases often seasonal?
Rodent-human contact increases during harvest or dry seasons.

What pathogen causes Lassa Fever?
Lassa fever virus.


How is Lassa fever transmitted?
By African soft-furred rats (Mastomys spp.) through ingestion or inhalation of items soiled with rat droppings or urine.

What type of genome does the Rabies virus have?
Negative sense single-stranded RNA (ssRNA), enveloped, with a helical capsid.
How is Rabies transmitted?
Through the saliva of infected animals via bites, contaminated water/food dishes, or inhaling aerosols from infected bats.
What cells does the Rabies virus target?
Muscle cells and neurons.

What receptors does Rabies virus bind to?
Acetylcholine receptor, neural cell adhesion molecule, or other unidentified nerve cell receptors.
How does the rabies virus reach the central nervous system after infection?
Retrograde transport of the virus up the nerve to the CNS.
rabies virus travels backwards along the nerves from the bite site toward the brain
What affects the length of the rabies incubation period?
How much virus was in the bite and how close the bite was to the brain.
Bit in leg = longer; bit in neck = shorter
What happens during the incubation phase of rabies?
Low virus replication in muscle cells (myocytes), no antibodies (Ab) produced, and the patient is asymptomatic.
Duration: 2 months to 1 year after the bite.

What are the symptoms during the prodrome phase?
Fever, nausea, vomiting, headache, lethargy, and pain.
Duration: 2-10 days.

What occurs during the neurologic phase?
Virus spreads in the CNS neurons and to highly innervated sites (eyes, glands). Antibodies are present in the CNS and serum. Symptoms include hydrophobia, pharyngeal spasms, hyperactivity, anxiety, depression, loss of coordination, confusion, and delirium.
Duration: 2-7 days.

What happens during the coma phase?
Cardiac arrest, hypotension, hypoventilation, secondary infection, and death.
Duration: 0-14 days.
How is rabies diagnosed?
History of exposure (bite or contact with infected animal)
Negri bodies found in Purkinje cells of the brain (post-mortem)
RT-PCR or immunofluorescent staining (post-mortem)

Why is natural immunity to rabies slow to develop?
Due to the virus’s slow replication and infection of immunoprivileged tissue.
How are Ebola and Marburg viruses transmitted?
Transmission is zoonotic but can also occur from human to human through most body fluids.

What are the suspected reservoirs of these viruses?
Primary: Bats
Secondary: Non-human primates
What is the viral attachment protein for Ebola and Marburg viruses?
The glycoprotein GP, which is membrane-anchored and secreted.


What are the primary target cells Ebola and Marburg of these viruses?
Myeloid cells, including dendritic cells, macrophages, and monocytes.


What causes the hemorrhagic fever in Ebolavirus disease?
Infected myeloid cells disseminate the virus to tissues. The liver, spleen, lung, and lymph nodes get infected, causing widespread tissue necrosis from cytopathic damage and cytokine release.

How is Ebolavirus treated?
Monoclonal antibodies to GP (Glycoprotein)
Convalescent sera (antibodies from survivors)
Type I IFN (Interferon)


How can Ebolavirus be prevented?
Vaccines: rVSV-ZEBOV (ERVEBO®)* and Ad26. ZEBOV/MVA-BN-Filo
Provides protection ONLY for Ebola Zaire, not Marburg virus
*Replication-competent attenuated vaccine. The virus is weakened but can still replicate to trigger an immune response without causing disease
